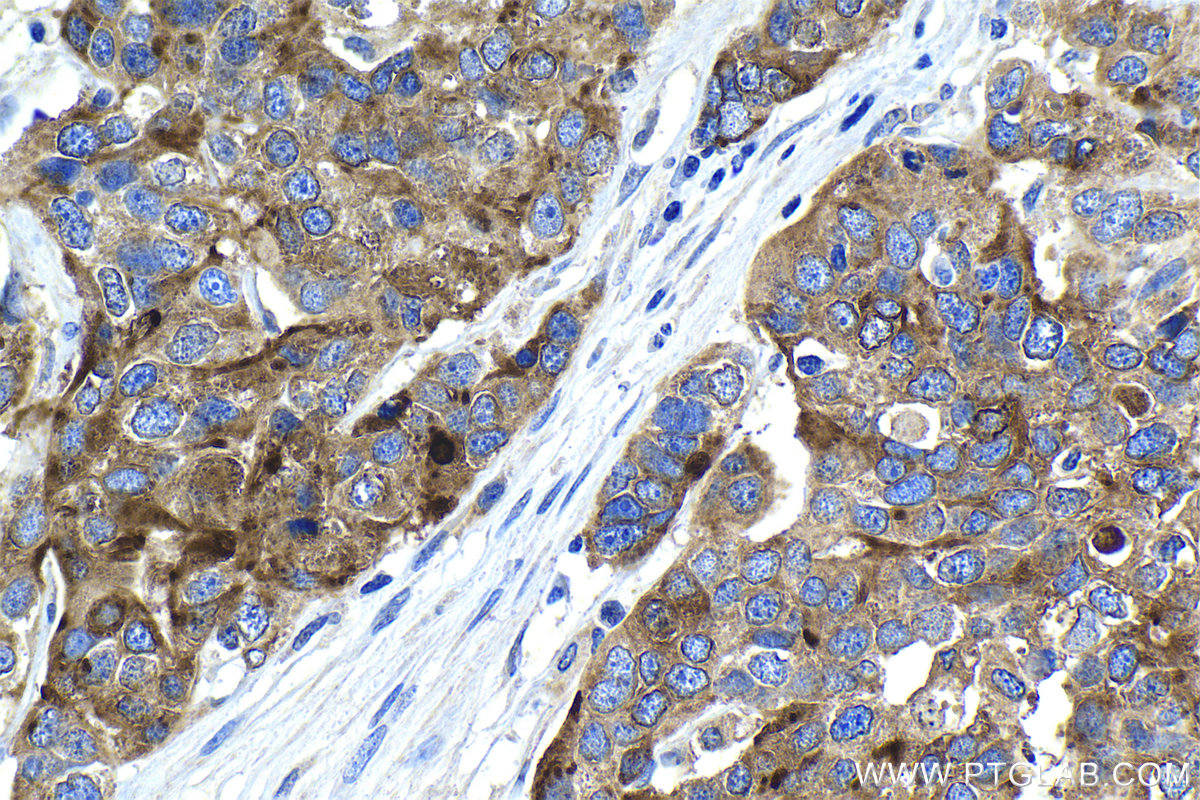

验证数据展示
经过测试的应用
| Positive IHC detected in | human ovary tumor tissue, human testis tissue Note: suggested antigen retrieval with TE buffer pH 9.0; (*) Alternatively, antigen retrieval may be performed with citrate buffer pH 6.0 |
| Positive IF/ICC detected in | MCF-7 cells |
推荐稀释比
| 应用 | 推荐稀释比 |
|---|---|
| Immunohistochemistry (IHC) | IHC : 1:250-1:1000 |
| Immunofluorescence (IF)/ICC | IF/ICC : 1:50-1:500 |
| It is recommended that this reagent should be titrated in each testing system to obtain optimal results. | |
| Sample-dependent, Check data in validation data gallery. | |
发表文章中的应用
| WB | See 3 publications below |
| IHC | See 2 publications below |
产品信息
14406-1-AP targets HE4 in WB, IHC, IF/ICC, ELISA applications and shows reactivity with human samples.
| 经测试应用 | IHC, IF/ICC, ELISA Application Description |
| 文献引用应用 | WB, IHC |
| 经测试反应性 | human |
| 文献引用反应性 | human, mouse, rat |
| 免疫原 |
CatNo: Ag5684 Product name: Recombinant human HE4 protein Source: e coli.-derived, PGEX-4T Tag: GST Domain: 21-124 aa of BC046106 Sequence: GFTLVSGTGAEKTGVCPELQADQNCTQECVSDSECADNLKCCSAGCATFCSLPNDKEGSCPQVNINFPQLGLCRDQCQVDSQCPGQMKCCRNGCGKVSCVTPNF 种属同源性预测 |
| 宿主/亚型 | Rabbit / IgG |
| 抗体类别 | Polyclonal |
| 产品类型 | Antibody |
| 全称 | WAP four-disulfide core domain 2 |
| 别名 | WFDC2, WAP5, WAP four-disulfide core domain protein 2, WAP four disulfide core domain protein 2, Major epididymis-specific protein E4 |
| 计算分子量 | 13 kDa |
| GenBank蛋白编号 | BC046106 |
| 基因名称 | HE4 |
| Gene ID (NCBI) | 10406 |
| RRID | AB_2878055 |
| 偶联类型 | Unconjugated |
| 形式 | Liquid |
| 纯化方式 | Antigen affinity purification |
| UNIPROT ID | Q14508 |
| 储存缓冲液 | PBS with 0.02% sodium azide and 50% glycerol, pH 7.3. |
| 储存条件 | Store at -20°C. Stable for one year after shipment. Aliquoting is unnecessary for -20oC storage. |
背景介绍
WFDC2, also named as HE4, is a member of the WFDC domain family. The WFDC domain, or WAP Signature motif, contains eight cysteines forming four disulfide bonds at the core of the protein, and functions as a protease inhibitor in many family members. HE4 is expressed in a number of normal tissues, and it is also highly expressed in a number of tumors cells lines, such ovarian, colon, breast, lung and renal cells lines. In some study, HE4 was referred to as a biomarker for ovarian carcinoma.
实验方案
| Product Specific Protocols | |
|---|---|
| IF protocol for HE4 antibody 14406-1-AP | Download protocol |
| IHC protocol for HE4 antibody 14406-1-AP | Download protocol |
| Standard Protocols | |
|---|---|
| Click here to view our Standard Protocols |
发表文章
| Species | Application | Title |
|---|---|---|
Biosens Bioelectron An ultrasensitive ratiometric electrochemiluminescence immunosensor combining photothermal amplification for ovarian cancer marker detection. | ||
Food Funct EPA and DHA differentially coordinate the crosstalk between host and gut microbiota and block DSS-induced colitis in mice by a reinforced colonic mucus barrier. | ||
RSC Adv Machine learning algorithms enhance the specificity of cancer biomarker detection using SERS-based immunoassays in microfluidic chips | ||
Iran J Pathol HE4, A New Potential Tumor Marker for Early Diagnosis and Predicting of Breast Cancer Progression. | ||
Cell Rep YAP targetome reveals activation of SPEM in gastric pre-neoplastic progression and regeneration |